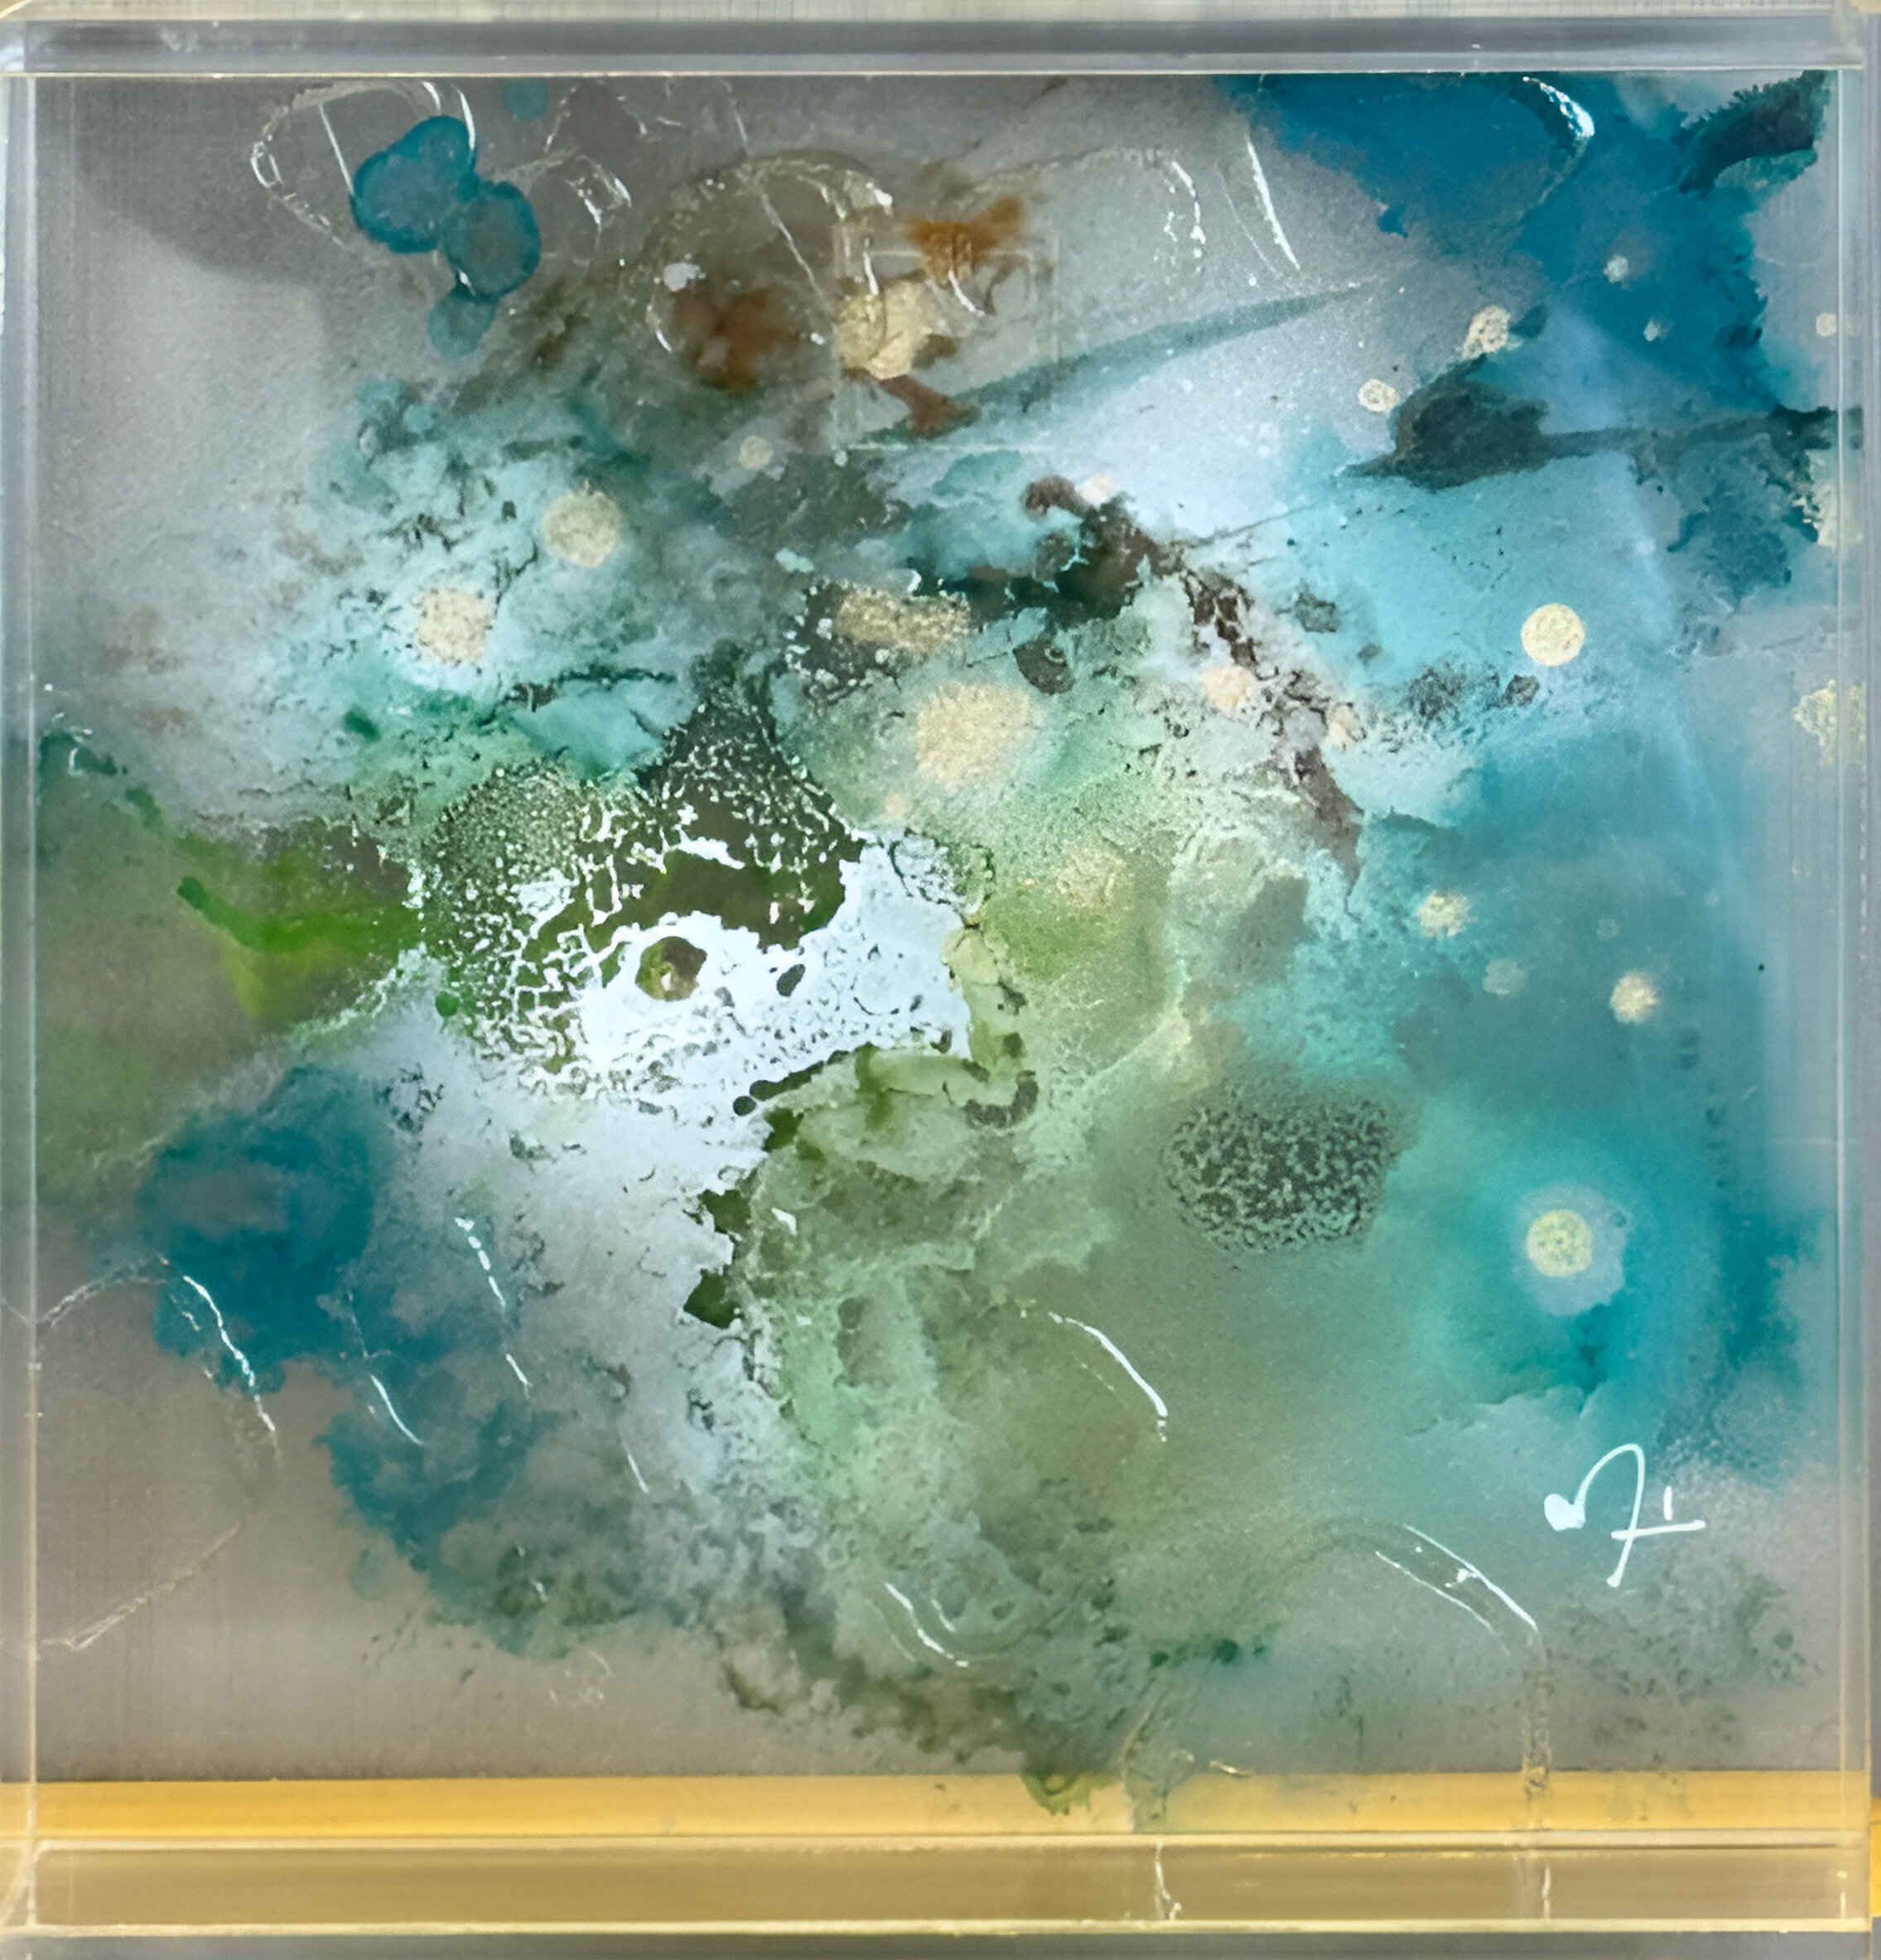

2025
Técnica mista 混合技法
20cm x 20cm
MARCELA LOPES
(マルセラ・ロペス)
por_marcela
Link para portfolio
Marcela Lopes (Cuiabá-MT, 1978) é artista plastica e curadora. Suas obras transitam entre pintura e objeto. Combina acrílica fluida, couro up-cycle, chapas transparentes de acrílico e materiais descartados para investigar a água como memória, afeto e potência de futuro nos biomas Cerrado, Pantanal e Amazônia.
Em 25 anos de trajetória, expôs no Palazzo Albrizzi (Veneza) e no Museu Nacional da República (Brasília). Assinou a curadoria da fachada “Memórias da Água” na CASACOR-MT 2024. Suas obras integram acervos no Brasil, EUA e Europa.

